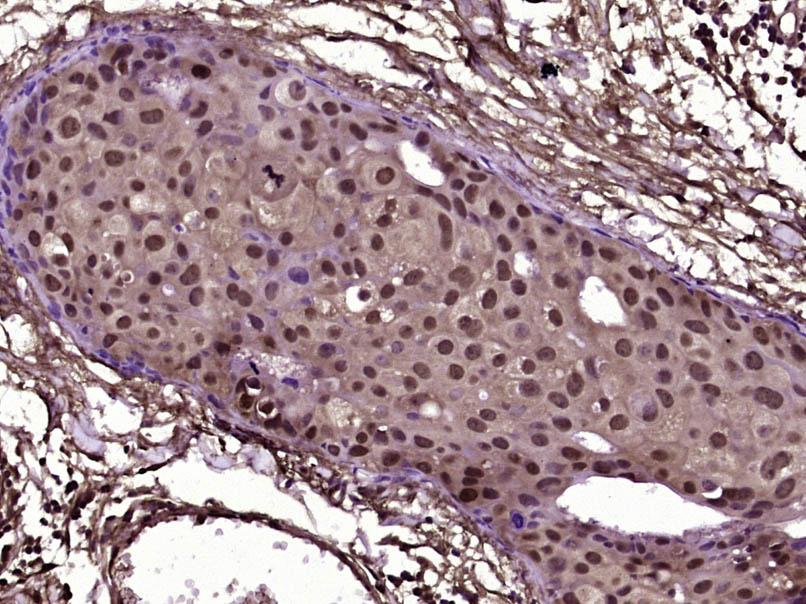
甲基化CpG结合蛋白抗体-bs-5915R

MBD1 Rabbit pAb (一抗) | Bioss

货号:bs-5915R
产品详情
相关标记
相关产品
相关文献
常见问题
概述
产品编号
bs-5915R
英文名称
MBD1 Rabbit pAb
中文名称
甲基化CpG结合蛋白抗体
英文别名
CXXC3; PCM1; RFT; MBD1_HUMAN; MBD1; CXXC-type zinc finger protein 3; Methyl-CpG-binding protein MBD1; Protein containing methyl-CpG-binding domain 1; methyl-CpG binding domain protein 1; protein containing MBD 1
抗体来源
Rabbit
免疫原
KLH conjugated synthetic peptide derived from human MBD1: 101-200/605
亚型
IgG
性状
Liquid
纯化方法
affinity purified by Protein A
克隆类型
Polyclonal
理论分子量
60 kDa
浓度
1mg/ml
储存液
0.01M TBS (pH7.4) with 1% BSA, 0.02% Proclin300 and 50% Glycerol.
SWISS
Gene ID
保存条件
Shipped at 4℃. Store at -20℃ for one year. Avoid repeated freeze/thaw cycles.
注意事项
This product as supplied is intended for research use only, not for use in human, therapeutic or diagnostic applications.
背景资料
DNA methylation, or the addition of methyl groups to cytosine bases in the dinucleotide CpG, is imperative to proper development and regulates gene expression. The methylation pattern involves the enzymatic processes of methylation and demethylation. The demethylation enzyme was recently found to be a mammalian protein, which exhibits demethylase activity associated to a methyl-CpG-binding domain (MBD). The enzyme is able to revert methylated cytosine bases to cytosines within the particular dinucleotide sequence mdCpdG by catalyzing the cleaving of the methyl group as methanol. MeCP2 and MBD1 (PCM1) are first found to repress transcription by binding specifically to methylated DNA. MBD2 and MBD4 (also known as MED1) were later found to colocalize with foci of heavily methylated satellite DNA and believed to mediate the biological functions of the methylation signal. Surprisingly, MBD3 does not bind methylated DNA both in vivo and in vitro. MBD1, MBD2, MBD3, and MBD4 are found to be expressed in somatic tissues, but the expression of MBD1 and MBD2 is reduced or absent in embryonic stem cells, which are known to be deficient in MeCP1 activity. MBD4 have homology to bacterial base excision repair DNA N-glycosylases/lyases. In some microsatellite unstable tumors MBD4 is mutated at an exonic polynucleotide tract.

产品应用
| 应用 | 已检合格种属 | 预测种属 | 推荐稀释比例 |
|---|---|---|---|
| IHC-P | Human, Rat | Mouse | 1:100-500 |
| IHC-F | Human, Rat | Mouse | 1:100-500 |
| IF | Human, Rat | Mouse | 1:100-500 |
交叉反应
交叉反应: Human, Rat (predicted: Mouse)
相关产品
暂无相关产品
靶标
基因名
MBD1
蛋白名
Methyl-CpG-binding domain protein 1
亚细胞定位
Nucleus speckle. Chromosome.
组织特异性
Widely expressed.
相似性
Contains 3 CXXC-type zinc fingers.
Contains 1 MBD (methyl-CpG-binding) domain.
Contains 1 MBD (methyl-CpG-binding) domain.
同靶标产品
相关文献
提示: 发表研究结果有使用 bs-5915R 时请让我们知道,以便我们可以引用参考文章。作为回馈,资料提供者将获得我们送上的小礼品。